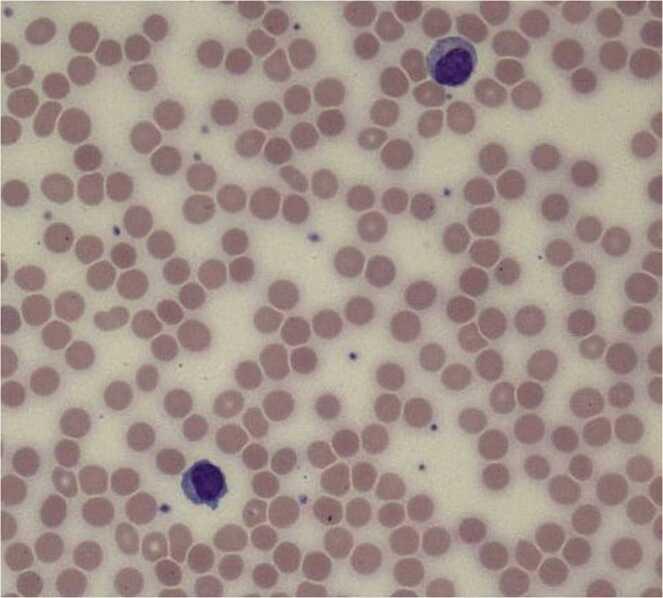

基孔肯雅病毒感染后的免疫介导性溶血
Immune mediated hemolysis after Chikungunya viral infection.
作者信息
Reuben Daniel Y, Lewis Eugene H
机构信息
Cancer Institute - Fairfield, Hartford HealthCare, St. Vincent's Medical Center, Bridgeport, CT, United States.
Frank H. Netter School of Medicine, Quinnipiac University, North Haven, CT, United States.
出版信息
IDCases. 2025 Aug 14;41:e02346. doi: 10.1016/j.idcr.2025.e02346. eCollection 2025.
This case describes a patient with recent Chikungunya viral infection and developing anemia after international travel to an endemic region. This viral exposure has become more common and occasionally seen in North America. Pertinent findings of the case are described. Post-viral hemolytic anemia was found 9 weeks after exposure in this patient. The patient's anemia persisted for 15 weeks until a full recovery of hemoglobin levels and hemolysis labs occurred. The patient was able to be followed expectantly. Post-viral symptom management generally employs supportive measures for symptomatic patients. Decisions regarding the evaluation and management of the anemia are described. Immune-mediated hemolysis has not been consistently reported in association with prior Chikungunya infection to date. As the incidence of Chikungunya infections has escalated in the last few decades it will be important for clinicians to understand this related post-viral hematologic occurrence with possible comorbidity.
该病例描述了一名近期感染基孔肯雅病毒且在前往流行地区国际旅行后出现贫血的患者。这种病毒暴露在北美已变得更为常见,偶尔可见。描述了该病例的相关发现。该患者在暴露9周后被发现患有病毒后溶血性贫血。患者的贫血持续了15周,直到血红蛋白水平和溶血实验室指标完全恢复。该患者能够接受观察等待。病毒后症状管理通常对有症状的患者采用支持性措施。描述了关于贫血评估和管理的决策。迄今为止,免疫介导的溶血与既往基孔肯雅病毒感染的关联尚未得到一致报道。鉴于在过去几十年中基孔肯雅病毒感染的发病率不断上升,临床医生了解这种相关的病毒后血液学情况及可能的合并症将很重要。